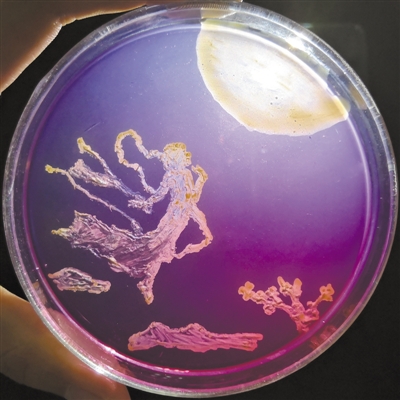
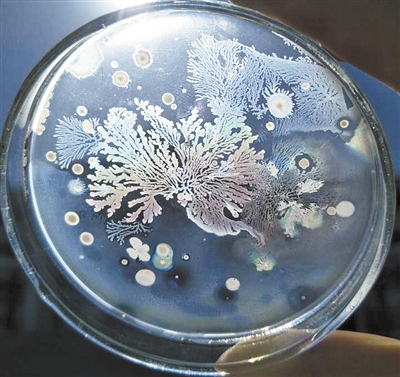

(受访者供图)
提到微生物,你第一时间会想起什么?是致人死亡的疾病,还是有益于肠道健康的菌群?在科学家的眼中,微生物有了另一个用途:“画画”的好材料。
色彩绚丽的嫦娥奔月图、季节变换春夏秋冬四季景色……近日,沈阳药科大学生命科学与制药学院的学生们在老师的指导下,以培养皿做画布,微生物做“颜料”,完成了一幅幅精美的艺术作品——其实,这些绚丽的色彩,是微生物自己“长”出来的。
别小看了这小小的微生物画作,它链接起了科学研究链条的两端,既能培养学生对学习本专业的兴趣,也可以在高大上的论文中扮演重要角色。
不同菌种产生不同颜色
直径9厘米的培养皿、按照流程消毒后的实验器材、稀释后的土壤标本……准备好这些材料,可以开始绘制一幅“画作”了。近日,沈阳药科大学生命科学与生物制药学院上演了一幕别开生面的画展:利用微生物作画。
在培养皿里,各种不同的菌株摇曳多姿,或是散落满地的洁白冰花,或呈现一片春花盛开的景色,或者是模仿秋天落叶的一片金黄;除了景色,九色鹿、蒙娜丽莎甚至校园的大门……红色的红球菌,黄色的黄杆菌,橙色的橙色单胞菌,白色的芽孢杆菌,有绿色绒毛的青霉菌,还有能产生各种颜色色素的链霉菌等等微生物,将它们的艺术之美演绎得淋漓尽致。
该校负责此次比赛的穆老师介绍,微生物作画的原理其实就是菌种的培养,从自然环境中找到合适的菌种,根据它们自身不同的颜色,利用无菌操作等方式,让菌种长成一幅漂亮的画。
菌株想要长成一幅画,最大的难点是对“颜料”的提纯。一旦混入了其他细菌或者纯化程度不足,就无法取得预料之中的色彩。想要解决这个问题,就必须按照科学研究的规律和实验规范来进行操作。
“实验室中各个步骤的无菌操作是对同学们的第一大要求。”沈阳药科大学生命科学与制药学院副院长、教授张怡轩介绍说,而参加本次画展的每一位同学,都严格遵守了实验要求:首先,实验中使用的培养皿、竹签等都要先经121℃高温高压湿热灭菌30分钟才能使用;其次,操作前要先将工作台空间中的微生物紫外照射30分钟杀灭,操作过程中也要避免微生物的侵入;最后,工作台上一直要吹动过滤过的无菌风,同时燃着酒精灯形成无菌区域。在此三重无菌保障下,一幅幅美丽的作品才能诞生。
从指导学生学习操作规范到挑选菌种、纯化培养,再到一个个带有颜色的斑点慢慢成长,最终长成一幅色彩斑斓的作品,前后共花费了一个多月的时间。“看着菌株一点点长大,最后按照我们的想法长成一幅画,这种感觉特别奇妙,充满了乐趣,”参赛选手、沈阳药科大学生物工程专业本科生王爽说。



×